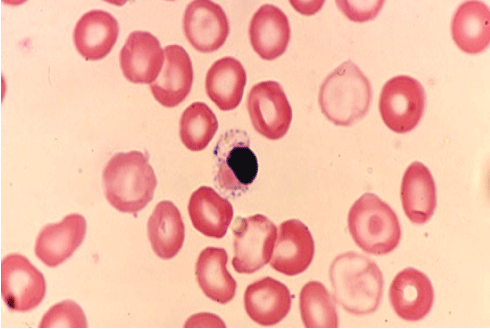
ٿيليسيميا

ٿيليسيميا
ٿيليسيميا: هن بيماريءَ جي تاريخ تمام گهڻي پراڻي ڏسجي ٿي. قديم زماني ۾ يونان ۾ هي بيماري عام رهي آهي. يوناني طب جي ڪتابن ۾ هن بيماريءَ جو گهڻو حوالو ملي ٿو. بنيادي طرح ٿيلسيميا (Thalassaemia) اکر بہ يوناني ٻوليءَ جو لفظ آهي. جيڪو لفظ موجودہ وقت ۾ ميڊيڪل سائنس ۾ بہ مروج ٿي ويو آهي. هن يوناني اکر جو ڇيد ڪبو تہ ٿيندو “THALASS” ٿلاس لفظ جي معنيٰ آهي سمنڊ ۽ “AEMIA” ايميا معنيٰ ”رت جي وروڌي حالت (Adverse condition of the blood)، جنهن جو مطلب ٿيندو تہ ”رت جي تمام گهڻي بگڙيل حالت“. اڄ بہ هي بيماري يونان ۽ ڀر پاسي وارن ملڪن ۾ عام آهي.
قديم زماني کانپوءِ هيءَ بيماري گهڻي ڀاڱي مصر (Egypt) ۾ ڏسڻ ۾ اچي ٿي. ڇو تہ مصر جي ممين (Mummies) (مصالحي ۾ محفوظ ٿيل لاشن) جي ڊي. اين. اي (DNA) ٽيسٽن جي جينياتي نقص (Genetic Defect) ۾ بہ هيءَ بيماري گهڻي ڀاڱي ملي ٿي. اڄ جي ميڊيڪل سائنس جي ماهرن جو اُهو خيال آهي تہ قديم زماني ۾ مصر جي ننڍڙن ٻارن جو وقت کان اڳ ۾ موت هن بيماري جي ڪري ٿيندو هو. اڄ بہ مصر جي مٿين علائقن ۾ هيءَ بيماري گهڻي ڀاڱي موجود آهي.
هينئر بہ رت جي هيءَ مهلڪ بيماري دنيا جي هر هڪ ڪنڊ ڪڙڇ ۾ موجود آهي. هن بيماريءَ جو گهڻو زور ميڊيٽرين سمنڊ (Mediterenian Sea) (يعني ڀونوچ/ ڳاڙهي سمنڊ) سميت روم جي سامونڊي ڪنارن تي وسندڙ ملڪن ۽ يورپ جي ڪيترن ملڪن ۾ آهي. دنيا ۾ گهڻي ۾ گهڻي هيءَ بيماري سِسِليءَ ۾ ٿئي ٿي. تنهن کانسواءِ ساردينا، ڪروشيا، قبرص ۽ مالديپ وارن علائقن ۾ پڻ هِن بيماريءَ جو گهڻو زور آهي. اُتر آفريقا، مڊل ايسٽ ۽ ايشيا وارا علائقا (ملڪ)، جن ۾ خاص ڪري بنگلاديش، سيلون، هندستان ۽ پاڪستان اچي وڃن ٿا، هن بيماريءَ جي اثر کان خالي ڪونهن. پاڪستان ۾ هيءَ بيماري هڪ سروي مطابق ملڪ جي سڄي آدمشماريءَ ۾ 6 کان 8 سيڪڙو آهي.
بيماريءَ ٿيڻ جا سبب (Etiology ):ٿيليسميا جي بيماريءَ جي باري ۾ ميڊيڪل سائنس اڃا تائين ڪامل سبب ڳولي ڪين سگهي آهي تہ هيءَ رت جي مهلڪ بيماري ٻارن کي ڪيئن ٿئي ٿي. ميڊيڪل سائنس جي مختلف ماهرن پنهنجا جدا جدا رايا ڏنا آهن تہ هيءَ بيماري هيٺين سببن جي ڪري ٿئي ٿي.
(1) موروثي بيماري (Hereditary Disease ):هيءَ بيماري ٻارن کي تڏهن ٿيندي آهي، جڏهن ٻارَ جي مائٽن جي رت جي ڳاڙهن جزن جي ڪيميائي مرڪب Hemoglobin Synthesis ۾ خلل جي ڪري رت جي لحمياتي سڻڀي مرڪب Polypeptic ۾ ٿورو يا مڪمل نقص هجي. جنهن جي نتيجي ۾ ٻارَ جي رت جي ڳاڙهن جزن (RBC) Erythrocytes جي بنيادي ذرڙن (Molecules) جي نظام ۾ تباهي ٿئي، جيڪا تباهي ٿيليسميا ٿيڻ جو سبب بڻجي ٿي. ياد رهي تہ رت جي هڪ ڳاڙهي جزي ۾ اٽڪل 280 ملين بنيادي ذرڙا ٿين ٿا.
جينياتي خلل (Genetic Defect ):هيءَ بيماري ٻارکي تڏهن ٿيندي آهي، جڏهن ماءُ يا پيءُ مان ڪنهن بہ هڪ جي (ڪڏهن ڪڏهن ٻنهي جي) رت ۾ موجود گلوبن (Globin) يعني پروٽين (Protein) جي گهٽتائي هجي، يا رت جي ڳاڙهن جزن ۾ پروٽين گهٽ ٺهي، جنهنڪري رت جا بنيادي ذرڙا (Molecules) ناقص ٺهندا. ان ڪري ٻارَ کي ڄمڻ کانپوءِ رت جي گهٽتائي (Anemia) ٿئي ٿي، جيڪا اڳتي هلي ٿيليسميا جي بيماري ٿيڻ جو سبب بڻبي آهي.
(3) پروٽين جي گهٽتائي (Deficiency of Protein ):ٻارَ جي پنھنجي رت ۾ ٻنهي قسم جون پروٽين هڪ “Alpha Protein” ۽ ٻي “Beta Protein” جي گهٽتائيءَ جي ڪري يا ٻنهي مان ڪنهن بہ هڪ پروٽين جي گهٽتائيءَ ڪري ٻار جي رت جا ڳاڙها جزا ٽٽي پوندا آهن، جيڪا حالت ٻار جي رت جي گهٽتائيءَ جو سبب بڻبي آهي. جنهن جي نتيجي ۾ ٻار کي ٿيليسميا ٿيندي آهي. هتي اُهو بہ ٻڌائجي تہ جيڪڏهن ٻارَ ۾ اُهي ٻئي پروٽين گهٽ هونديون يا مرڳو نہ هونديون تہ ٻارَ جي آڪسيجن ۽ ڪاربان ڊاءِ آڪسائيڊ جو عمل درست ٿي نہ سگهندو آهي، جنهن جي ڪري ٻار کي ساھہ ۾ تنگي، سھڪ ۽ دل تي وزن پوندو آهي. جيڪا علامت ٿيليسميا جي مريض جي نازڪ حالت سمجهي ويندي آهي.
(4) تِريءَ جو ناقص فعل (Desfunction of Spleen ):گهڻن سبب جي ڪري تِري پنهنجو قدرتي فعل درست ڪري نہ سگهندي آهي. جنهن جي ڪري جسم ۾ ڪتب آيل رت جا ڳاڙها جزا جيئن جو تيئن ويندا آهن. تريءَ ۾ گڏ ٿيندا، جنهن جي ڪري هڪ تہ تِري وڌي ويندي آهي. (جنهن کي هيانچي يا ٻرهل جي بيماري سڏبو آهي)، ٻيو جيئن تہ تِري پنھنجي قدرتي فعل جيوڙن جي ڳڙڪائڻ “Phagocyte” هيٺ، ڪتب آيل رت جي ڳاڙهن جزن مان سڀني زهريلن ۽ ڪيميائي ناقص مادن کي ڳِهي ناس ڪندي آهي. پوءِ رت جي ڳاڙهن جزن ۾ موجود سڀني ڪارگر ڪيميائي مادن کي الڳ ڪري انهن کي جسم جي لاڳاپيل عضون ڏي موڪليندي آهي. اهڙيءَ طرح رت جا ڳاڙها جزا ٻيهر صحتمند ٿي جسم ۾ رت جي دوري ۾ شامل ٿي ويندا آهن. هاڻي تِري جڏهن پنهنجو قدرتي فعل (ڪم) ڪري نہ سگهندي آهي تہ ٻارَ جي رت جي ڳاڙهن جزن جون ڪيميائي تبديليون “Metabolism” ٿي نہ سگهنديون آهن، جنهن جي نتيجي ۾ ٻارَ کي ٿيليسميا جي بيماري ٿيندي آهي. ياد رهي تہ ٻار کي ڪهڙي بہ قسم جي ٿيليسميا جي بيماري هوندي آهي تہ ان ۾ ٻار جي هر حال ۾ تِري وڌيل هوندي آهي.
(5) ناقص هڏن جي مِکُ (Deficient Bone Marrow ): ٻار جي ڊگهن هڏن (Long Bones) جنهن ۾ ران جو ڊگهو هڏو (Femur) ۽ پٺيءَ جو ڊگهو هڏو (Fibula) اچي وڃن ٿا. انهن ۾ ٺهندڙ ڳاڙهي مِکُ جي ناقص ٺھڻ ڪري ٻار کي ٿيليسميا جي بيماري ٿيندي آهي. ياد رهي تہ ڳاڙهي مِک اصل ۾ رت جا ڪچا ڳاڙها جزا هوندا آهن. اُهي رت جا ڪچا ڳاڙها جزا جڏهن جيري ۾ پهچندا آهن تہ جيرو انهن کي رت جا پختا ڳاڙها جزا ٺاهيندو آهي. جيڪي بعد ۾ رت جي دوري ۾ شامل ٿي ويندا آهن.
(6) ناقص جيوگهرڙا (Defective Cells ):ٻارُ جڏهن ماءُ جي پيٽ ۾ اڃا ڪچو ٻار (Foetus) هوندو آهي تہ مھڙ وارن پنجن مهينن تائين ٻارَ جو رت تريءَ ۽ جيري ۾ ٺهندو آهي تہ ان وقت ئي رت جي ڳاڙهن جزن جا جِيوَگهرڙا ناقص ٺھڻ ڪري ٻارَ کي ڄمڻ کانپوءِ ٿيليسمياجي بيماري ٿئي ٿي.
(ٻ) ٿيليسميا جا قسم (TYPES OF THALASSAEMIA ):
(1) عام ٿيليسميا (Hetrozygote Minor Thalassaemia ):هن قسم جي ٿيليسمياگهڻي ڀاڱي موروثي يا جينياتي ٿيندي آهي. هن قسم جي ٿيليسميا کي نر ماد واري (Autosomal Thalassaemia) پڻ چئبو آهي. هن قسم جي ٿيليسميا جيتوڻيڪ ٻار سان سڄي عمر گڏ هلندي (Carries) آهي، پر گهٽ نقصانڪار هوندي آهي.
(2) مهلڪ ٿيليسميا (Homozygus Major Thalassaemia ):هن قسم جي ٿيليسميا ٻار کي تڏهن ٿيندي آهي جڏهين خود ٻار جي پنھنجي رت ۾ خلل هوندو آهي. هن قسم جي ٿيليسميا تمام گهڻي مهلڪ هوندي آهي. جنهن ۾ ٻارَ پنھنجي زندگي وڃائي ويهندا آهن.
ٿيليسميا جون علامتون (CLINICAL SYMPTOMS ):
(1) ٻار کي رت جي گهٽتائي Anemia هوندي آهي.
(2) ٻارَ جو منهن ڦڪو ۽ ڦلڙو ٿي ويندو آهي ۽ منهن تي آموس هوندي آهي.
(3) ٻار جي بُک مُئل هوندي آهي.
(4) ٻار جي جسماني اوسر دير سان ٿيندي آهي
(5) ٻار جي منهن جي هڏن ۾ سور ٿيندو آهي، ڪيترن ٻارن جي منهن جا هڏا وڌي يا ٽيڏا ٿي ويندا آهن.
(6) ٻار جي تِري وڌيل، سڳل هوندي آهي. ڪيترن ٻارن جي تريءَ ۾ سور هوندو آهي. جڏهن هيءَ بيماري مهلڪ بڻجي ويندي آهي تہ مريض ۾ هي علامتون ظاهر ٿينديون آهن.
(7) ٻار جي جسم جون مشڪون ڪمزور ٿي سُسي وينديون آهن. تنهنڪري ٻارَ جو جسم ڦلڙو، ٻانھون ۽ ٽنگون سنهيون ٿي وينديون آهن. ڪيترن ٻارن جون ٽنگون ڦري وينديون آهن.
(8) ٻار کي سائي يرقان ٿي پوندو آهي
(9) تِري پنهنجو قدرتي فعل ڇڏي ڏيندي آهي.
(10) ٻار جي تِري وڌي وڃڻ ڪري ۽ پنهنجو قدرتي فعل نہ ڪرڻ ڪري دل ۽ جيرو وڌي ويندا آهن، يا جيري جي تاندورن جي سوس جي بيماري (Liver Cirrhosis) ٿي پوندي آهي.
(11) ٻارَ جون بڪيون ڪم ڪرڻ ڇڏي ڏينديون آهن.
(12) ٻار کي پيشاب ڳوڙهي رنگ جو ايندو آهي. جنهن ۾ تمام گهڻي پروٽين (البيومين) ايندي آهي.
(ت) ليبارٽري ٽيسٽ (PARHOLOGICAL TEST ):هتي اسانجي ملڪ ۾ هن مرض جي تشخيص (Diagnosis) جي لاءِ تہ رڳو رت جي CBC، يا Blood CP يا وري Haemotology Test ورتي ويندي آهي. پر سڌريل ملڪن ۾ ٿيليسميا جي ڄاڻ لاءِ آئمنيوٽڪ فلوڊ ٽيسٽ Amnoitic Fluid Test ورتي ويندي آهي. جنهن ۾ ٻار جي اور Placenta يا ٻار ۽ ائمنيوٽڪ فلوڊ جنهن ٿيلهيءَ SAC ۾ هوندا آهن تہ ان ٿيلهيءَ مان پاڻيٺ جو نمونو وٺي اها ٽيسٽ ڪئي ويندي آهي تہ ٻارَ کي ٿيليسميا جي بيماري آهي يا نہ؟ جي آهي تہ اها ڪهڙي قسم جي آهي، عام ٿيليسميا آهي، يا مهلڪ ٿيليسمياآهي.
مونجهاري واريون (نازڪ) حالتون (COMPLICATE CONDITIONS):
(1) هٿرادو رت چاڙهڻ (Blood Trasfussion) ڪري رت ۾ آئرن (Iron) جو مقدار وڌي ويندو آهي. جنهن جو سبب تِريءَ جو وڌي وڃڻ (Splenomegogy) ڪري تري پنهنجو قدرتي فعل ڪري نہ سگهڻ آهي. جڏهين رت ۾ آئرن جو مقدار وڌي ويندو آهي تہ جسم جي گهڻن عضون (خاص ڪري دل، جيري ۽ بڪين) جي اوڄن (Tissues) کي ڇيهو رسندو آهي، تنهنڪري اُهي عضوا ڪم ڪرڻ ڇڏي ڏيندا آهن.
تِري وڍي ڇڏڻ SPLENECTOMY: جڏهن تري گهڻن سببن جي ڪري پنهنجو قدرتي فعل درست ڪري نہ سگهندي آهي تہ ان ۾ سڄي جسم جا زهريلا ، ڪيميائي مادا ۽ جيوڙا اچي گڏ ٿيندا آهن، جنهن جي ڪري تري وڌي ويندي آهي. جنهن کي وڍي ڪڍي ڇڏبو آهي. نتيجي طور جسم ۾ زهريلا، ڪيميائي مادا ۽ زهريلا جيوڙا گڏ ٿيڻ ڪري، جسم ۾ روڳ واريون حالتون پيدا ٿينديون آهن، جنهن جي ڪري ٻارَ جو رت زهريلو ٿي ويندو آهي.
(2) ٻار جي رت ۾ جڏهن پروٽين جي گهٽتائي ٿيندي آهي، يا رت جي ڳاڙهن جزن ۾ پروٽين مرڳو نہ هوندي تہ ان حالت ۾ ٻار جي آڪسيجن ۽ ڪاربان ڊاءِ آڪسائيڊ جو عمل درست ٿي نہ سگهندو آهي، جنهن جي ڪري ٻار کي ساھہ ۾ تنگي، سھڪ ۽ دل تي وزن ٿي پوندو آهي.
(3) ٻار جي جسم ۾ جڏهين ٿيليسميا جي بيماري ڊيگهاري ٿي ويندي آهي تہ ان حالت ۾ ٻارن جي هڏن جي ڀُرڻ (Osteoprosis) جو عمل ٿيندو آهي.